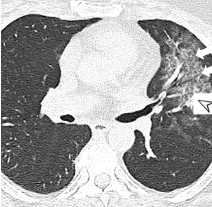
Chest computer tomography (CT) with ground-glass opacities
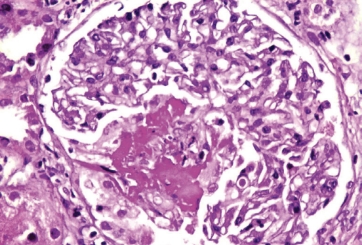
Kidney biopsy showing necrotizing pauci-immune glomerulonephritis

Indication: TAVNEOS (avacopan) is indicated as an adjunctive treatment of adult patients with severe active anti-neutrophil cytoplasmic autoantibody...
Read moreIndication: TAVNEOS (avacopan) is indicated as an adjunctive treatment of adult patients with severe active anti-neutrophil cytoplasmic autoantibody (ANCA)-associated vasculitis (granulomatosis with polyangiitis [GPA] and microscopic polyangiitis [MPA]) in combination with standard therapy including glucocorticoids. TAVNEOS does not eliminate glucocorticoid use.
Read lessDo you wish to leave the site?

There are 56 clinical features, grouped into 9 organ systems plus an “Other” category, each of which is given a numerical value according to its perceived clinical relevance as decided by expert consensus.3,16,18 Additionally, the BVAS:
Renal
Nervous system
Chest
Abdominal
Cardiovascular
Cutaneous
Mucous membranes and eyes
Ear/nose/throat
The 9th clinical item is “general” which includes myalgia, arthralgia/arthritis, fever, weight loss.16
A higher total BVAS equates to a more active vasculitic disease at the time of evaluation.16,18Abdominal
Cutaneous
Nervous system
Cardiovascular
ENT
Renal
Chest
Mucous membranes/Eyes
General
Can only be scored on the first assessment.
BVAS = Birmingham Vasculitis Activity Score; GPA = granulomatosis with polyangiitis; HPF = high-power field; MPA = microscopic polyangiitis; RBC = red blood count.
| ANCA-associated vasculitis |
PR3-ANCA (mostly c-ANCA) |
MPO-ANCA (mostly p-ANCA) |
Other |
|---|---|---|---|
| GPA | 75% | 20% | 5% ANCA-negative |
| MPA | 30% | 60% | 10% ANCA-negative |
| ANCA-associated vasculitis |
GPA |
|---|---|
|
PR3-ANCA (mostly c-ANCA) |
75% |
|
MPO-ANCA (mostly p-ANCA) |
20% |
| Other | 5% ANCA-negative |
| ANCA-associated vasculitis |
MPA |
|---|---|
|
PR3-ANCA (mostly c-ANCA) |
30% |
|
MPO-ANCA (mostly p-ANCA) |
60% |
| Other | 10% ANCA-negative |

A full ANCA profile can be used in diagnosing
severe active GPA and MPA.
Biopsy is another supportive tool that can be confirmatory, particularly in cases with renal, pulmonary, or skin involvement, but treatment should not necessarily be delayed simply to get a biopsy.
Renal biopsy in a patient with severe active AAV showing
This page provides a few examples of queries on electronic medical records or practice management systems that may be helpful in identifying appropriate patients for TAVNEOS®.
|
ICD-10 codes associated with GPA or MPA |
|
|---|---|
| M31.3 | Granulomatosis with Polyangiitis (GPA)* |
| M31.30 | Granulomatosis with Polyangiitis (GPA) without renal involvement |
| M31.31 | Granulomatosis with Polyangiitis (GPA) with renal involvement |
| M31.7 | Microscopic Polyangiitis (MPA) |
| 177.6 | Unspecified Arteritis† |
| 177.82 | Anti-neutrophil cytoplasmic antibody (ANCA) vasculitis |
GPA is formerly known as Wegener’s granulomatosis.
The diagnosis is related to ANCA-associated vasculitis or GPA/MPA, specifically, and confirmed or awaiting confirmation using one or more lab tests: ANCA serum/biopsy/urinalysis.
The following codes represent generalized symptoms that are common manifestations of GPA and MPA:
| ICD-10 Code | Manifestation |
|---|---|
| Vasculitic rash with systemic features | |
| L98.9 | Dermatosis |
| R23.3 | Purpuric |
| R50.9 | Fever |
| Respiratory symptoms | |
| R04.2 | Hemoptysis |
| R06.00 | Dyspnea |
| R06.02 | Shortness of breath |
| R05.9 | Cough |
| J45.909 | Asthma |
| J44.9 | Chronic |
| Renal disease | |
| N05.9 | Glomerulonephritis |
| ICD-10 Code | Manifestation |
|---|---|
| Ear, nose, throat/upper airway symptoms | |
| J32.9 | Sinusitis |
| J01.81 | Recurrent |
| H92.0 | Earache |
| H90.2 | Conductive hearing loss |
| M95.0 | Saddle nose |
| J95.5 | Subglottic stenosis |
| Eye symptoms | |
| H15.00 | Scleritis |
| H53.2 | Diplopia |
| Nerve Symptoms | |
| R20.2 | Paresthesia |
| G62.9 | Neuropathy, neuropathic |
The information on this page is informational and is not intended to be instructive with respect to clinical decision-making or billing and coding. Healthcare providers are solely responsible for clinical decisions and ensuring the accuracy and validity of all billing and claims. This is not a guarantee of coverage or reimbursement for any product or service.
Do you wish to leave the site?
Serious hypersensitivity to avacopan or to any of the excipients.
Hepatotoxicity: Serious cases of hepatic injury have been observed in patients taking TAVNEOS, including life-threatening events. Obtain liver test panel before initiating TAVNEOS, every 4 weeks after start of therapy for 6 months and as clinically indicated thereafter. Monitor patients closely for hepatic adverse reactions, and consider pausing or discontinuing treatment as clinically indicated (refer to section 5.1 of the Prescribing Information). TAVNEOS is not recommended for patients with active, untreated, and/or uncontrolled chronic liver disease (e.g., chronic active hepatitis B, untreated hepatitis C, uncontrolled autoimmune hepatitis) and cirrhosis. Consider the risks and benefits before administering this drug to a patient with liver disease.
Serious Hypersensitivity Reactions: Cases of angioedema occurred in a clinical trial, including 1 serious event requiring hospitalization. Discontinue immediately if angioedema occurs and manage accordingly. TAVNEOS must not be readministered unless another cause has been established.
Hepatitis B Virus (HBV) Reactivation: Hepatitis B reactivation, including life-threatening hepatitis B, was observed in the clinical program. Screen patients for HBV. For patients with evidence of prior infection, consult with physicians with expertise in HBV and monitor during TAVNEOS therapy and for 6 months following. If patients develop HBV reactivation, immediately discontinue TAVNEOS and concomitant therapies associated with HBV reactivation, and consult with experts before resuming.
Serious Infections: Serious infections, including fatal infections, have been reported in patients receiving TAVNEOS. The most common serious infections reported in the TAVNEOS group were pneumonia and urinary tract infections. Avoid use of TAVNEOS in patients with active, serious infection, including localized infections. Consider the risks and benefits before initiating TAVNEOS in patients with chronic infection, at increased risk of infection, or who have been to places where certain infections are common.
The most common adverse reactions (≥5% of patients and higher in the TAVNEOS group vs. prednisone group) were nausea, headache, hypertension, diarrhea, vomiting, rash, fatigue, upper abdominal pain, dizziness, blood creatinine increased, and paresthesia.
Avoid co-administration of TAVNEOS with strong and moderate CYP3A4 enzyme inducers. Reduce TAVNEOS dose when co-administered with strong CYP3A4 enzyme inhibitors to 30 mg once daily. Consider dose reduction of CYP3A4 substrates when coadministering TAVNEOS. Co-administration of avacopan and 40 mg simvastatin increases the systemic exposure of simvastatin. While taking TAVNEOS, limit simvastatin dosage to 10 mg daily (or 20 mg daily for patients who have previously tolerated simvastatin 80 mg daily for at least one year without evidence of muscle toxicity). Consult the concomitant CYP3A4 substrate product information when considering administration of such products together with TAVNEOS.
TAVNEOS is available as a 10 mg capsule.
TAVNEOS (avacopan) is indicated as an adjunctive treatment of adult patients with severe active anti-neutrophil cytoplasmic autoantibody (ANCA)-associated vasculitis (granulomatosis with polyangiitis [GPA] and microscopic polyangiitis [MPA]) in combination with standard therapy including glucocorticoids. TAVNEOS does not eliminate glucocorticoid use.
Please see Full Prescribing Information and Medication Guide for TAVNEOS.
To report a suspected adverse event, call 1-833-828-6367. You may report to the FDA directly by visiting www.fda.gov/medwatch or calling 1-800-332-1088.
important safety information Contraindications Serious hypersensitivity to avacopan or to any of the excipients.
Warnings and Precautions Hepatotoxicity: Serious cases of hepatic injury have been observed in patients taking TAVNEOS, including life-threatening events. Obtain liver test panel before initiating TAVNEOS, every 4 weeks after start of therapy for 6 months and as clinically...